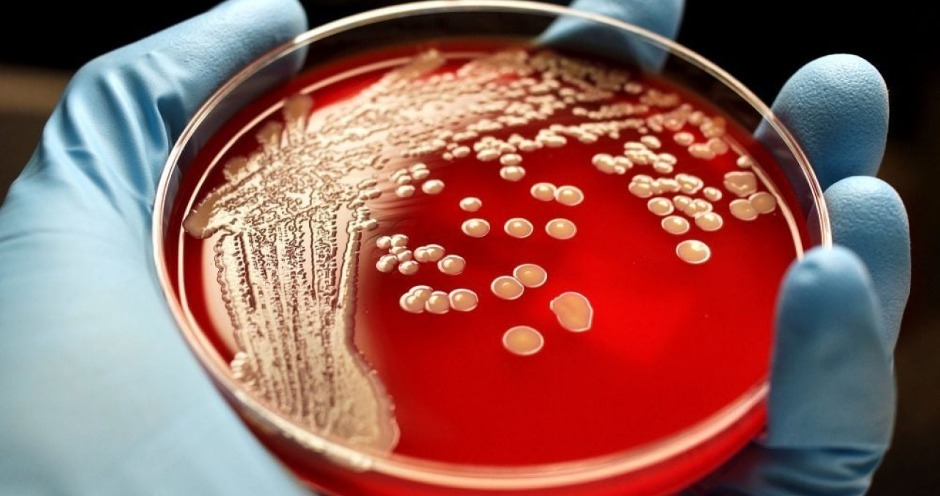

Вспышка сибирской язвы зафиксирована на севере Казахстана
Отраслевое информационное агентство ElDala сообщает, что в селе Приречное Костанайской области Казахстана введен карантин по сибирской язве. Особо опасное инфекционное заболевание диагностировано у крупного рогатого скота. Карантин введен в понедельник, 5 августа.
В прошлом году случай сибирской язвы были зафиксированы в Акмолинской, Жамбылской, Туркестанской и Карагандинской областях. Один человек скончался.
На итоговой коллегии 2023 года министр сельского хозяйства Казахстана Айдарбек Сапаров подверг острой критике работу ветеринарных служб. Как выяснилось, на местах не проводилась вакцинация животных от сибирской язвы, отсутствовал учет кратности прививок среди молодняка, многие скотомогильники находились в неудовлетворительном состоянии после наводнений. Кроме того, были выявлены факты бесконтрольного перемещения и неполной идентификации скота.
Весной 2024 года деятельность ветеринарной службы Костанайской области проверяла природоохранная прокуратура, выявившая множество нарушений — в том числе фиктивную вакцинацию, сокрытие заболеваний при составлении официальной отчетности, несоблюдение правил хранения и использования вакцин.
Парейдолия - это распространенная зрительная иллюзия, при которой мозг, стремясь распознать знакомые образы, «дорисовывает» базовые...
Новинки Останкино (ТМ "Папа Может", "Останкино", "Коровино") на выставке ПРОДЭКСПО 2026 ...
Бренд-шеф компании "Мираторг" Дмитрий Лазько рассказал Мясному Эксперту о новинках компании представленных на выставке "Продэкспо 2026" прошедшей...
Технологии для бизнеса. Микаэль Алиев, основатель компании «Профи Био» ...
Коллеги цифровизаторы-интеграторы, айтишники и все умеющие отличать штрих-коды от...
Уважаемые коллеги здравствуйте. скажите пожалуйста кто уже подал заявку на участие в пилотном...
ну или креазот и деготь вам на стол для вашей печени. Фото снято в ноябре 2025...
Здравствуйте. Остаётся щетина после обесволашивания. Пробовали увеличение циклов, замену бил,...
Здравствуйте, уважаемые! Посоветуйте, пожалуйста. Предлагают по 80000 рублей две термокамеры...
Добрый вечер всем. Когда то писал письмо в ВНИИМП по данным книгам, которые они издавали, на...









